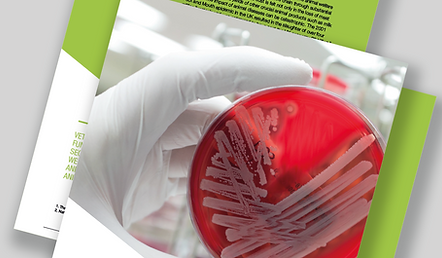
ML200429 AgriAlert Press banners9.png

top of page
BLACKGRASS FACTS
BLACKGRASS FACTS
BLACKGRASS FACTS
BLACKGRASS FACTS
Contact us today on +44 (0) 1234 780020
or email agrialert@mologic.co.uk;
Alison.wakeham@globalaccessdx.com
LATEST NEWS AND READING MATERIAL

EXPERTS IN YOUR FIELD
Whether you’re at the start of your journey with a great rapid point-of-care diagnostic idea, or need to scale up manufacturing, we have the expertise, creativity and resources you need. We’re the lateral flow pioneer and the partner you’re looking for at any, or every stage of development.
Mologic. We’re with you every step of the way.
Contact us today on +44 (0) 1234 780020 or email agrialert@mologic.co.uk to find out how we can help you.
CONTACT US
CAN'T FIND WHAT YOU ARE LOOKING FOR? LEAVE YOUR DETAILS AND WE’LL BE IN TOUCH ASAP.
bottom of page